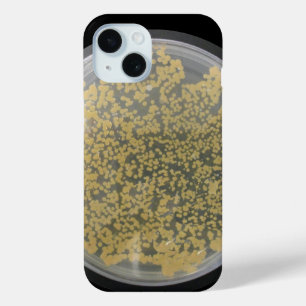
Bakterienkulturstein Bedeckt mit Kolonien Case-Mate iPhone Hülle

Beliebte Mikrobiologie Geschenke
Beliebte Mikrobiologie Geschenke
2’623 Ergebnisse
Bacteria Socks Socken
PreisCHF 24.65
Labrador Armbanduhr
PreisCHF 58.45
Bakteriophagen Trinkflasche
PreisCHF 30.15
Mikrobiologe Bacteria Microscope Tasche
PreisCHF 28.00
Bakterien Personalisiert iPhone Hülle
PreisCHF 25.95
Gram Stain Socks Socken
PreisCHF 22.05
Wissenschaft Leggings
PreisCHF 77.95
Mikrobiologen lieben die Kleinen Schlüsselanhänger
PreisCHF 21.20
Mikrobiologen lieben die Kleinen Flaschenöffner
PreisCHF 4.65
Remüde Mikrobiologe, täusche mich nicht. Schnapsglas
PreisCHF 9.05
Mikrobiologen lieben die Kleinen Armbanduhr
PreisCHF 59.70
CALM UND STUDY MIKROBIOLOGIE behalten Steinuntersetzer
PreisCHF 19.55
Gram Stain Kugelschreiber
PreisCHF 6.40
Liebe-Bakterien-reiche Verteiler der Kultur
PreisCHF 24.60
Paramecia Paisley Protozoan Biology Science Schürze
PreisCHF 32.25
Nicht Mikroben, die man auf dem falschen Planeten Glas
PreisCHF 17.80
Bakterien aus der Mikrobiologie winzig Jumbo-Tasse
PreisCHF 32.90
Ich spiele mit Bakterien den ganzen Tag Untersetzer
PreisCHF 39.15
Frauen gehören zum Labrador - Biologie-DNA Notizbuch
PreisCHF 32.45
Mikrobiologie-Muster Kissen
PreisCHF 47.15
Bakterielle Teller Socken
PreisCHF 22.05
Mikrobiologie Magnet
PreisCHF 7.20
Moderne aqua blaue Biochemie Leben ist komplex Notizbuch
PreisCHF 33.55
Gram Stain Zubehörtasche
PreisCHF 19.45
DNA Science Biologe Biologie 11 Edelstahlflasche
PreisCHF 34.25
Funny Labrador tech zitiert Labortechniker Spaß Kissen
PreisCHF 46.65
Mikrobiologiermuster Socken
PreisCHF 24.65
Magnet für die Liebe der Mikrobiologie
PreisCHF 7.60
i Liebe Mikrobiologie Mousepad
PreisCHF 21.50
Mikrobiologie im Blau Keramik Ornament
PreisCHF 21.35
Mikrobiologie.. Coole Kinder Button
PreisCHF 5.75
Mikrobiologen lieben die Kleinen Tragetasche
PreisCHF 13.25
FriedensLiebe-Mikrobiologie Mousepad
PreisCHF 23.25
Staph aureus Culture Magnet
PreisCHF 4.55
Mikrobiologie im Blau Button
PreisCHF 4.15
Der Geruch der Mikrobiologie am Morgen Magnet
PreisCHF 6.70
Blut-Parasit Trypanosoma Button
PreisCHF 4.15
Mikrobiologie Science Art Luck Mousepad
PreisCHF 21.00
Blut-Parasit Trypanosoma Keramikornament
PreisCHF 21.35
Coronavirus Button
PreisCHF 3.90
Bakteriophagen Notizblock
PreisCHF 15.05
Gib' uns Feedback!
Wenn du Hilfe benötigst oder eine Frage an unseren Kundendienst hast, besuche bitte unser Hilfecenter.
Zuletzt angesehene Produkte